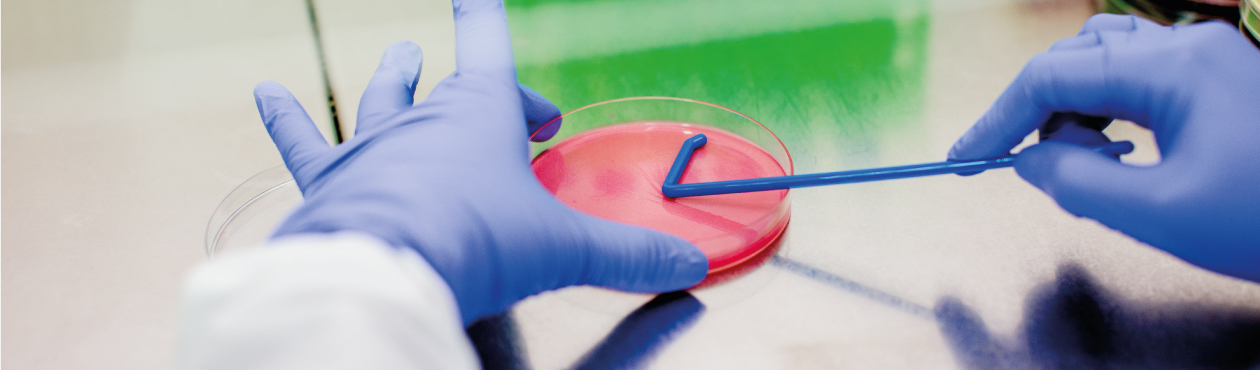

La pandemia impulsó, como una especie de ‘boom’, el desarrollo y ajuste de dispositivos y productos que en el mercado colombiano están relacionados con la eliminación de todo tipo de agentes infecciosos como bacterias, hongos o hasta el virus SARS-CoV-2 causante de la COVID-19.
Ese panorama se evidencia que, en los últimos seis meses de 2020, el Instituto Colombiano de Medicina Tropical (ICMT) de la Universidad CES en Medellín reportó un incremento del 60% en las solicitudes de empresas o particulares para evaluar cualquier tipo de producto o dispositivo con capacidad bactericida o fungicida.
“Este es un mercado que ha venido en crecimiento en los últimos años, pero que incrementó con la pandemia. Sin embargo, es importante resaltar que, estos productos deben estar en constante desarrollo y evaluación para que puedan cumplir con las necesidades y retos del mercado”, aseguró el Doctor en Ciencias, Giovanny Torres Lindarte, del ICMT.
Muestra de ello, es el aumento significativo de evaluaciones que se han ejecutado desde comienzos de la pandemia a la fecha en el Laboratorio de Microbiología Industrial del ICMT. En este espacio se trabaja solo con bacterias y hongos. Cuentan con una amplia variedad de cepas de acuerdo con el uso que tendrá el producto. Por ejemplo, si será usado como un antiséptico o un desinfectante en la industria de alimentos, a nivel hospitalario o en la limpieza y desinfección del hogar.
“El Laboratorio no solo presta este servicio, sino que además asesora y acompaña a sus clientes en la selección de las bacterias y hongos a evaluar, según el uso del producto o dispositivo, así como en la interpretación de los resultados, permitiéndoles a los clientes verificar su desempeño y tomar decisiones de mejora o control de los productos”, añadió Luis Ernesto López Rojas, director del ICMT.
Los análisis se practican en un laboratorio que cumple con las condiciones de bioseguridad para la manipulación de microorganismos, por parte de personal capacitado en este tipo de prácticas, como profesionales en microbiología con posgrados (Maestría y Doctorado) en la misma área y con amplia experiencia en la aplicación de estas técnicas de laboratorio.
¿Cómo se hace la evaluación?
Los jabones, geles, cosméticos, productos para la limpieza y desinfección del hogar y ambientes hospitalarios, así como, equipos desarrollados para la desinfección de prendas de vestir, alimentos, equipaje o cualquier producto de uso diario como llaves, gafas; son algunos de los ejemplos de productos o dispositivos que se evalúan a diario.
Para la evaluación, el primer paso que se ejecuta es la selección del grupo de bacterias y hongos a retar de acuerdo con las necesidades de uso del producto o dispositivo. Luego, se identifica la norma nacional o internacional que se ajuste a los parámetros requeridos y al final se socializan los resultados y se le brinda una asesoría al solicitante.
“El laboratorio está en capacidad de evaluar productos o dispositivos bajo condiciones simuladas o reales de uso, permitiéndole a los solicitantes contar con alternativas de ensayos que les permita conocer los comportamientos de los productos fuera del laboratorio o dentro de estos, pero bajo condiciones de uso muy cercanas a la realidad”, precisó el doctor Torres Lindarte.
También, el ICMT está habilitado por el Laboratorio Departamental de Salud de Antioquia para el procesamiento de más de 300 pruebas diarias PCR para el diagnóstico de la COVID-19 en sus laboratorios de los municipios de Sabaneta, en el Valle de Aburrá; y Apartadó en la región de Urabá.

Universidad CES
Cl. 10a #22 – 04
Medellín, Antioquia

Para más información ingresa
a nuestro sitio web:
www.ces.edu.co
Deja un comentario